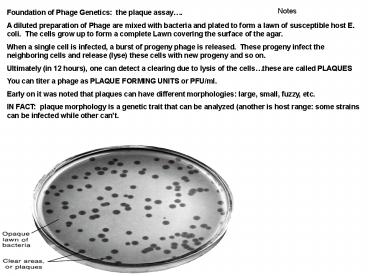

Notes PowerPoint PPT Presentation
1 / 20
Title: Notes
1
- Notes
Foundation of Phage Genetics the plaque
assay. A diluted preparation of Phage are mixed
with bacteria and plated to form a lawn of
susceptible host E. coli. The cells grow up to
form a complete Lawn covering the surface of the
agar. When a single cell is infected, a burst of
progeny phage is released. These progeny infect
the neighboring cells and release (lyse) these
cells with new progeny and so on. Ultimately
(in 12 hours), one can detect a clearing due to
lysis of the cellsthese are called PLAQUES You
can titer a phage as PLAQUE FORMING UNITS or
PFU/ml. Early on it was noted that plaques can
have different morphologies large, small, fuzzy,
etc. IN FACT plaque morphology is a genetic
trait that can be analyzed (another is host
range some strains can be infected while other
cant.
2
- Phage crosses Two markers used
- h- can infect two different host strains
- h can infect only one strain
- r- gives large plaques (rapid lysis)
- r give small plaques (slow lysis)
- The cross Infect strain 1 at high MOI to
ensure that all cells get multiple phage inputs
( mixed infection), analyze progeny phage by
plaque assays on a mixture of strains 1 and 2.
All four possible genotypes inferred by simply
evaluating plaque morphology as in Table 7-3 and
Fig.7-24.
MOI multiplicity of infection or of input
phage per cell
Explanation of Genotype
Clear h- lysis of both 1 and 2 strains Small
r gives slow lysis Cloudy h only infects
strain 1Large r- means rapid lysis Cloudy h
only infects strain 1small r gives slow
lysis Clear h- lyses both 1 and 2
strainsLarge r- means rapid lysis ( large
plaque morphology)
3
- Notes
Explanation of Genotypes
Clear h- lysis of both 1 and 2 strains Small
r gives slow lysis Cloudy h only infects
strain 1Large r- means rapid lysis Cloudy h
only infects strain 1small r gives slow
lysis Clear h- lyses both 1 and 2
strainsLarge r- means rapid lysis ( large
plaque morphology)
Very Cool!
4
Infect strain 1 at high MOI to ensure that all
cells get multiple phage inputs ( mixed
infection), analyze progeny phage by plaque
assays on a mixture of strains 1 and 2.
- Features of the phage cross
- This is a valid method to evaluate map distances.
- Reciprocal crosses can be analyzed in this system
(unlike in E. coli where you need double or even
crossovers) - Resolving power is HUGE since large numbers of
phage can be analyzed and screened in a short
time. Awesome power of genetics revealed.
These are the parental or input genotypes being
recombined in this cross
Strain 1 mixed infection
Recombinants will therefore be h r and h- r-
r
x
h
Recombination to give single crossover event
Can enumerate both wild type and mutant phage
r
h
5
- Seymour Benzers rII system with T4 in the
1950s The upgrade - Benzer figured out a model system to analyze very
rare recombination events usig the rII locus. - r rapid lysis was mapped to two loci rI and
rII - The real power of his model was that rII mutants
displayed different host range specificity on E.
coli B and K(l) as host cells. - Both strains can be used to distinguish wt and
mutant phage genotype - E. coli B allows both wt and mutant to
replicate but plaques are different size - rII mutants give large plaques wt rII (also
called rII) produce small plaque morphology. - E. coli K
- rII mutants do not replicate or form plaques, but
wt (rII) can plaque
E. coli strain B is said to be permissive for rII
mutants
E. coli strain K is non- permissive for rII
mutants
rII mutants therefore are said to be
conditional and can grow under one set of
conditions but not another (i.e., E. coli strain
B vs. K)now lets see how this model system works
in practice.
6
- Selection and crossing in Benzers T4 rII system
Calculation of Rcbn Freq. - Goal cross two rII mutants and analyze/recover
WT phage recombinants. - Doubly infect permissive B with the two test rII
mutants (a) - Phage replicate/recombine and do what phage do
best (lyse cells, release a crop of various
recombinants plus parentals). - Analyze the progeny If you plaque out on B,
you will see mostly large plaques (rII mutants)
and occasionally rII wt (small). - If recombinants are say 1-5 you probably could
find these small/ragged plaques if you screened
enough however, IF recombinants are rare (0.1)
it would be pretty hard to find since many many
more large plaques would predominate.imagine
trying to find a small plaque phenotype in this
mess!
PFU on B for each mutant phage
However, if you plate on K, where ONLY wt phage
plaque, your screen is much more powerful since
only wt phage can grow!
Thus, even if RF is less than 0.01 you can still
detect wt phage why is that you might ask?....
7
Great resolving power T4 rII
- Typical phage titers in the 109 to 1010/ml.
- If RF ( wt pfu) is 0.1 a million phage
- If RF is 0.01 100,000 phage
- If RF is 0.001 10,000
- if RF is 0.0001 1000 phage you get the
picture! - IN THEORY, we could find 1 phage in 109-1010
awesome power. - HOW DOES THIS WORK IN PRACTICE (to quantify Rcbn
Freq.) - After we do the cross (in B), we determine the RF
as follows - 1. Plaque assay progeny on K ( wt only) and B
(the total yield of wt and mutant phage) - RF PFU on K x 2 divided by total PFU on B
- Why x2? Since double mutants from reciprocal
exchange should be present in equal amounts to wt
phage (cannot detect these double mutants)
8
What about controls?
- Total yield on Bshows that the phage cross
worked well as expected - Need also to plate each parental input lysate
onto E. coli K as well any plaques detected
would be due to reversion or back mutations. - This ensures that wt phage appear as a result of
recombination and NOT revertants.
9
Transduction Phage mediated gene transfer
- The Discovery
- Lederberg/Zinder Marker alleles were
transferred between strains (similar to
conjugation experiments).Difference in the
U-Tube analysis, with various pore size, P22
phage was discovered to mediate gene transfers. - Verified by filterability size antibody
sensitivity resists hydrolytic enzymesunlike
conjugation - Discovered gene transfer mediated by a phage or
TRANSDUCTION phage pick-up or acquire host
DNA, transfers it to another host. - Two Types Generalized and Specialized.
10
Generalized Transduction Phage head packages
host DNA (which is degraded by phages like P1 and
P22) -Progeny phage infect the next host
bacterium merodiploid results -By nature
virtually any gene can be transmitted in this
wayhence generalized
Faulty head stuffing accounts for the results
seen. Thus, linkage data derived from
co-transduction frequencies Linked genes have
high probability of yielding cotransductants.
Ex cross of met and arg in E. coli Grow P1 in
metarg host, analyze progeny in a met-arg- host
and determine of met colonies that are also arg
The frequency of phage with host DNA generally
0.01 or less
11
Application of P1 transduction From
co-transduction , can deduce relative gene
orders and with enough markers generate a
complete linkage map. -Note that the
contransduction is higher for closely linked
genes.
12
Markers must be within about 1.5 minutes to be
co-transduced.
1 min is the time required to move a marker in 1
min of an HFR mating.
Expt 1 leu is very close to azi but distant
from thr Expt 2 thr and leu linked closer than
aziThus, possibility 2 more logical Expt. 3
selecting for both leu and thr no azi found,
thus 2 confirmed (the transduced piece never
includes azi).
Another example ab host donor into an ab
recipient. Various transductants are possible
ab ab ab By selecting for one
donor marker, we can determine linkage linkage of
the other Selecting for a the map distance
between a and b is single gene transductants
divided by the total of transductants. In this
case (ab) (a b) (ab)
(ab) x 100 or for b (a b) (ab)
x 100
13
Lysogeny
- Phage can classified as being
- Virulent (always lytic and release a crop of
progeny phage) - Temperate or lysogenic (process is called
lysogeny) lytic under some conditions but
usually exist in a lysogenic state as a prophage
integrated into the genome. - Note that lysogenic bacteria resist infection by
another phage (or superinfection).
X
14
Basis of lysogeny phage l -Exists as an
integrated element always near the gal region E.
coli. -In fact, the integrated prophage behaves
like a single gene locus -Interrupted mating
conjugation (with HFR), phage enters at a
specific time, consistently (again, near
gal). F x F- (l) crosses Lysogenic
Recombinants recoveredF(l) x F- crosses No
Lysogenic Recombinants recoveredphage enters a
lytic cycle and no recombination is
possible. Similarly HFR (l) x F- immediately
triggers prophage induction and lysis. This is
called zygotic induction
l prophage
- prophage imposes a sort of immune status so
that superinfection with incoming phage is not
possible. - -Due to a cytoplasmic repressor
- Repressor not present in this cell therefore
incoming phage immediately induced to lytic
state.
15
How phage integrates
Integrate through the att site between gal and
bio
Lysogenic state maintained by phage encoded
repressor
Prophage
Chromosome is longer genetic distance between
gal and bio increases.Also, deleting flanking
bacterial DNA can also delete phage DNA
16
Specialized Transduction
Phage carries SPECIFIC genomic DNA sites (gal or
bio). How it works
Defective ldgald means that the phage is
defective
att site
17
- Chromosome mapping in E. coli
- -When new genes identified and you wish to map
here is how - HFR strains give a rough map location to 10-15
map units. - Fine tune location with P1 generalized
transduction mapping (gets it closer and finer
resolution).
E. coli genetic map about 100 genes mapped in
1963... After 27 years of refinement (1990) have
used these methods to map 1400 genes.
18
In 1997, genome sequenced and a physical map of
devised based on the sequence data.
The genetic map 60-61 min As of 1990
The Physical map based on DNA sequence of the E.
coli genome 1997 RED regulatory function DARK
BLUE DNA related functions (DNA rep., Rcbn.,
etc.)
19
(No Transcript)
20
LECTURE 4continued